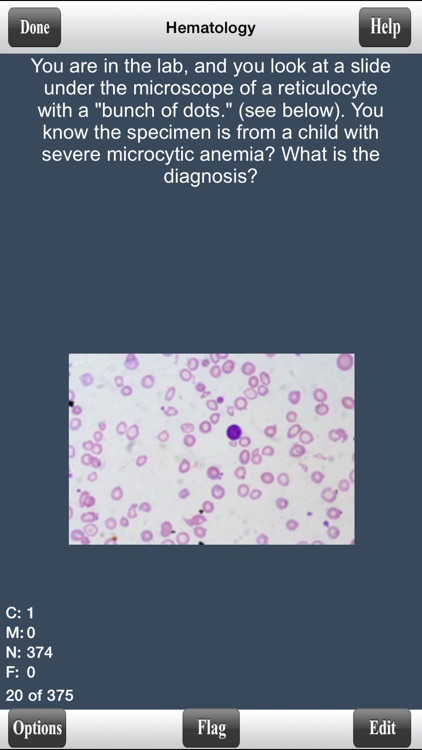
COMLEX Level 1 Flashcards Lite screenshot-3

This is a fully functional version of COMLEX Level 1 Flashcards

COMLEX Level 1 Flashcards Lite



What is it about?
This is a fully functional version of COMLEX Level 1 Flashcards. It has only a few select cards for your evaluation. However, all options and features are active.

App Screenshots

App Store Description
This is a fully functional version of COMLEX Level 1 Flashcards. It has only a few select cards for your evaluation. However, all options and features are active.
This is the Lite version for COMLEX Level 1 Pathology Flashcards. The full version has over 3000 different COMLEX Level 1 to master the material to do well on the COMLEX exam to get the residency of your choice.
The program itself offers various features and options for a great and convenient learning environment which include:
- Ability to Randomize cards
- Can Flag cards for later use
- Grade cards by using gestures
- Study only missed cards, only new cards, only correct cards, flagged cards, or study all cards
- Study all categories or selected categories
- Timed mode to automatically flip card and advance cards.
- Ability to edit and delete cards
- Convenient statistics panel to see progress
- Can change background color and text color
- Can change text size
- Can see back of card first
If you enjoy our Lite version, you can purchase our full version on the app store.
Try it out!
AppAdvice does not own this application and only provides images and links contained in the iTunes Search API, to help our users find the best apps to download. If you are the developer of this app and would like your information removed, please send a request to takedown@appadvice.com and your information will be removed.